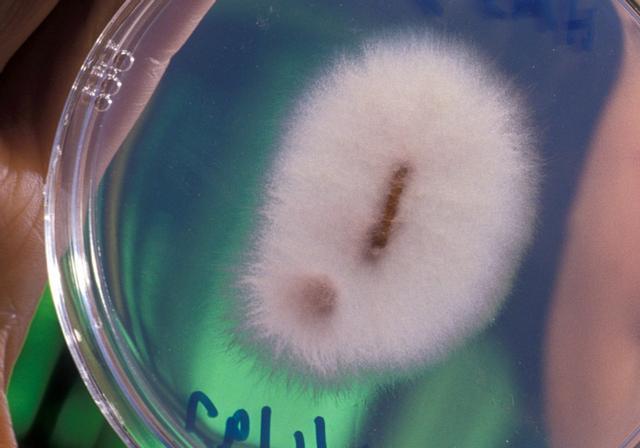

愛吃黃金的生物,科學家們有一個大膽的想法,能成真就太棒了數千年以來,黃金一直都是被視為財富的象徵,也是最重要的一般等價物,現在人類和挖掘出的黃金數量是有限的,畢竟黃金的儲存量是有限的,其實黃金的屬性十分穩定,也會和其他物質發生反應。

我們能挖到的直接就是金粒或者金沙最近。現在科學家就發現了一種喜歡吃黃金的生物,真的是讓人大吃一驚,科學家們也有了一種特殊的想法,他們在情況中發現,這種金閃閃的微生物尖孢鐮刀菌。

這種真菌會以黃金為食,而且會從粉紅色變成金黃色,吃了黃金之後,他們的體型會變的更大。人們為了挖尋找金礦挖掘金礦,總是要費很大的力氣的,但是科學家們發現他這種真菌居然可以直接吸收黃金。
而且是不是可以大面積繁殖這種細菌,讓他們去吸收黃金,然後我們再把這些細菌回收起來提煉呢,甚至可以讓他來處理電子汙染廢品,然後把裡面的黃金收集起來,是不是就像擁有一座移動金礦的情況呢?